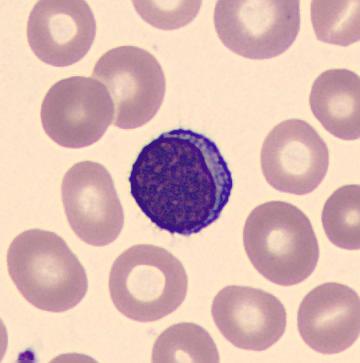
Die Funktion von Monozyten im Immunsystem und ihre Bedeutung für die Infektabwehr

Monozyten sind eine Art von weißen Blutkörperchen, die eine wichtige Rolle bei der Abwehr von Infektionen und Entzündungen im Körper spielen. Sie gehören zu den sogenannten „Fresszellen“ des Immunsystems und können Krankheitserreger sowie abgestorbene Zellen phagozytieren. Darüber hinaus sind Monozyten auch an der Reparatur von Gewebeschäden beteiligt. Ihr Vorhandensein und ihre Aktivität können daher wichtige Indikatoren für den Gesundheitszustand einer Person sein.
- Kreative Ideen: Geldgeschenke zum 18. Geburtstag selber basteln
- Das Alter von Alfons Schuhbeck: Ein Blick auf die Lebensjahre des Star-Kochs
- Entdecke den intensiven Geschmack von Trüffel – eine kulinarische Delikatesse
- Wellensittich-Spielplatz selber bauen: Kreative Bauanleitung für Vogelspielplatz
- Wie lange darf man ohne TÜV fahren?
Die Funktion von Monozyten im Immunsystem und ihre Bedeutung für die Infektabwehr
Funktion der Monozyten im Immunsystem
Monozyten sind eine Art von weißen Blutzellen, die eine wichtige Rolle im Immunsystem spielen. Sie gehören zur Gruppe der sogenannten Fresszellen oder Phagozyten. Ihre Hauptaufgabe besteht darin, Krankheitserreger wie Bakterien, Viren und Pilze zu erkennen, aufzunehmen und zu vernichten.
Der Prozess der Phagozytose
Um Krankheitserreger zu bekämpfen, wandern Monozyten aus dem Blut in das Gewebe. Dort verwandeln sie sich in Makrophagen, die spezialisierte Fresszellen sind. Die Makrophagen haben die Fähigkeit, Krankheitserreger durch den Prozess der Phagozytose aufzunehmen. Dabei umschließen sie die Erreger mit ihrem Zellkörper und bilden eine sogenannte Phagosommembran um sie herum. Anschließend fusioniert das Phagosom mit Lysosomen, wodurch Verdauungsenzyme freigesetzt werden, die den Krankheitserreger zerstören.
Bedeutung für die Infektabwehr
Die Funktion der Monozyten als Fresszellen ist entscheidend für die Infektabwehr des Körpers. Durch ihre Aktivität tragen sie dazu bei, Krankheitserreger zu eliminieren und somit Infektionen einzudämmen. Ein Anstieg der Monozytenzahl im Blut, auch als Monozytose bezeichnet, kann ein Indikator für eine aktuelle Infektion oder eine chronische Entzündung sein. Dieser Anstieg zeigt an, dass das Immunsystem aktiv gegen die Krankheitserreger vorgeht.
Zusammenfassend spielen Monozyten eine wichtige Rolle in der Immunabwehr des Körpers. Als Fresszellen sind sie in der Lage, Krankheitserreger zu erkennen und zu vernichten. Ein Anstieg der Monozytenzahl im Blut kann auf eine Infektion oder Entzündung hinweisen und zeigt die Aktivität des Immunsystems an. Durch ihre Funktion unterstützen Monozyten die gezielte Infektabwehr und tragen zur Aufrechterhaltung der Gesundheit bei.
Monozyten: Die größten Zellen im Blut und ihre Rolle bei der Bekämpfung von Bakterien und Entzündungen

Was sind Monozyten?
Monozyten sind die größten Zellen im Blut und gehören zur Gruppe der weißen Blutkörperchen, auch Leukozyten genannt. Normalerweise machen sie etwa zwei bis acht Prozent aller Leukozyten aus. Monozyten haben eine wichtige Funktion im Immunsystem und spielen eine entscheidende Rolle bei der Bekämpfung von Infektionen.
Die Rolle von Monozyten bei der Infektabwehr
Monozyten können aus dem Blut in das Gewebe wandern und sich dort in sogenannte Fresszellen, auch Makrophagen genannt, verwandeln. Diese Fresszellen besitzen die Fähigkeit, Bakterien, Zelltrümmer und veränderte Eiweiße aufzunehmen und zu entsorgen. Dadurch tragen sie maßgeblich zur Abwehr von Infektionen bei.
Erhöhte Monozytenzahlen bei Entzündungen
Eine erhöhte Anzahl an Monozyten im Blut, auch als Monozytose bezeichnet, kann ein Hinweis auf chronische Entzündungen sein. Bei solchen Entzündungsprozessen werden vermehrt Monozyten gebildet und ins Blut abgegeben. Dies ist eine normale Reaktion des Körpers auf entzündliche Prozesse.
Zusätzlich kann es zu einem isolierten Anstieg der Monozyten nach einer schweren Verminderung anderer weißen Blutkörperchen, wie beispielsweise bei einer Leukopenie, kommen. Dies wird als positives Zeichen für eine Erholung des Knochenmarks interpretiert.
Es ist auch bekannt, dass Monozyten andere Zellen einschließen können, wie zum Beispiel Erythrozyten bei einer Hämolyse oder Pilze und Parasiten bei bestimmten Infektionen wie der Leishmaniose.
Insgesamt spielen Monozyten eine bedeutende Rolle bei der Bekämpfung von Bakterien und Entzündungen im Körper. Ihre Fähigkeit, sich in Fresszellen umzuwandeln und schädliche Substanzen zu beseitigen, macht sie zu wichtigen Akteuren im Immunsystem.
Monozytose: Ursachen, Symptome und mögliche Folgen erhöhter Monozytenwerte im Blut

Ursachen für eine Monozytose
Eine Erhöhung der Monozytenzahlen im Blut, auch als Monozytose bezeichnet, kann verschiedene Ursachen haben. Chronische Entzündungen wie beispielsweise rheumatoide Arthritis, Morbus Crohn oder Colitis ulcerosa können zu einer erhöhten Anzahl von Monozyten führen. Auch Infektionen durch Bakterien oder Parasiten können zu einer Monozytose führen. Darüber hinaus kann eine Stressreaktion des Körpers auf Glukokortikoide ebenfalls zu einem Anstieg der Monozytenwerte führen.
Symptome und mögliche Folgen einer erhöhten Anzahl von Monozyten im Blut
In den meisten Fällen verursacht eine erhöhte Anzahl von Monozyten keine spezifischen Symptome. Oft wird die Veränderung nur bei Routineblutuntersuchungen festgestellt. In einigen Fällen können jedoch Symptome wie Müdigkeit, Abgeschlagenheit oder allgemeines Unwohlsein auftreten.
Eine erhöhte Anzahl von Monozyten im Blut kann auf eine zugrunde liegende Erkrankung hinweisen, insbesondere wenn sie mit anderen Veränderungen im Blutbild einhergeht. Es ist wichtig, die genaue Ursache der Monozytose zu ermitteln, um gegebenenfalls eine entsprechende Behandlung einzuleiten und möglichen Komplikationen vorzubeugen.
Mögliche Folgen einer erhöhten Anzahl von Monozyten im Blut hängen von der zugrunde liegenden Ursache ab. Bei chronischen Entzündungen kann eine langfristige Aktivierung des Immunsystems zu Gewebeschäden führen. Infektionen können sich ebenfalls verschlimmern und schwerwiegender verlaufen, wenn das Immunsystem nicht optimal funktioniert. Daher ist es wichtig, eine erhöhte Anzahl von Monozyten im Blut ärztlich abklären zu lassen, um mögliche Folgen rechtzeitig zu erkennen und zu behandeln.
Die Wandlung der Monozyten zu Fresszellen (Makrophagen) und ihre Aufgabe bei der Entsorgung von Zelltrümmern

Wandlung zu Makrophagen
Monozyten sind die größten Zellen im Blut und spielen eine wichtige Rolle im Immunsystem. Nachdem sie aus dem Blut in das Gewebe gewandert sind, verwandeln sie sich dort in sogenannte Fresszellen, auch Makrophagen genannt. Diese Transformation ermöglicht es den Monozyten, ihre spezielle Funktion bei der Entsorgung von Zelltrümmern wahrzunehmen.
Aufgabe bei der Entsorgung von Zelltrümmern
Die Hauptaufgabe der Makrophagen besteht darin, verschiedene Arten von Abfallstoffen und Zelltrümmern aufzunehmen und zu entsorgen. Dazu gehören unter anderem Bakterien, Viren, Pilze sowie veränderte oder abgestorbene körpereigene Zellen. Die Makrophagen erkennen diese Fremdstoffe oder beschädigten Zellen durch spezielle Rezeptoren auf ihrer Oberfläche.
Nachdem die Makrophagen die Fremdstoffe oder Zelltrümmer aufgenommen haben, verdauen sie diese mithilfe von Enzymen und anderen chemischen Substanzen. Dadurch werden die schädlichen Stoffe unschädlich gemacht und können anschließend ausgeschieden werden. Zusätzlich nehmen die Makrophagen auch eine wichtige Rolle in der Immunabwehr ein, indem sie Antigene präsentieren und so andere Immunzellen aktivieren können.
Zusammenfassend kann gesagt werden, dass die Wandlung der Monozyten zu Fresszellen (Makrophagen) eine wichtige Voraussetzung für ihre Aufgabe bei der Entsorgung von Zelltrümmern ist. Durch ihre Fähigkeit, verschiedene schädliche Stoffe aufzunehmen und zu verdauen, tragen die Makrophagen maßgeblich zur Aufrechterhaltung eines gesunden Immunsystems bei.
Der Zusammenhang zwischen Monozyten und dem blutbildenden System: Leukämie und andere Erkrankungen

Leukämie
Leukämie ist eine Erkrankung des blutbildenden Systems, bei der es zu einer unkontrollierten Vermehrung von unreifen Blutzellen kommt. Dies führt zu einem erhöhten Anteil an unreifen Monozyten im Blut. Diese Monozyten können ihre Funktion als Fresszellen nicht richtig erfüllen und sind weniger effektiv in der Bekämpfung von Bakterien, Zelltrümmern und veränderten Eiweißen. Die Überproduktion von unreifen Monozyten kann auch die Produktion anderer Blutzellen beeinflussen und zu weiteren Störungen im Blutbild führen.
Andere Erkrankungen
Neben Leukämie gibt es auch andere Erkrankungen des blutbildenden Systems, die mit Veränderungen der Monozyten einhergehen können. Zum Beispiel kann eine chronische Entzündung im Körper dazu führen, dass vermehrt Monozyten ins Blut abgegeben werden. Diese reaktive Form der Monozytose ist ein Zeichen dafür, dass der Körper versucht, die Entzündung zu bekämpfen. Bei Stressreaktionen, beispielsweise auf Glukokortikoide, kann es ebenfalls zu einer erhöhten Anzahl von Monozyten kommen.
Eine isolierte Erhöhung der Monozyten nach einer schweren Leukopenie (Verminderung der Anzahl von weißen Blutzellen) kann ein positives Zeichen für eine Erholung des Knochenmarks sein. In solchen Fällen deutet dies darauf hin, dass das blutbildende System wieder normal funktioniert und die Produktion von Blutzellen, einschließlich Monozyten, wieder angemessen ist.
Es ist wichtig zu beachten, dass Veränderungen in den Monozytenzahlen im Blut nicht immer auf eine schwerwiegende Erkrankung hinweisen. Sie können auch durch andere Faktoren wie Infektionen, Entzündungen oder Stress verursacht werden. Eine genaue Diagnose und weitere Untersuchungen sind erforderlich, um die Ursache für die Veränderungen der Monozyten festzustellen und eine angemessene Behandlung einzuleiten.
Reaktive Formen der Blutbildveränderungen: Wie ein isolierter Anstieg der Monozyten auf eine Knochenmarkserholung hindeuten kann

1. Erhöhte Monozytenzahlen bei chronischen Entzündungen und Stressantwort
Ein erhöhter Anteil von Monozyten im Blut, auch bekannt als Monozytose, kann bei verschiedenen Zuständen auftreten. Zum einen kann dies auf das Vorliegen einer chronischen Entzündung hinweisen. Die Monozyten wandern aus dem Blut in das Gewebe und verwandeln sich dort in Fresszellen, die Bakterien, Zelltrümmer und veränderte Eiweiße aufnehmen und entsorgen können.
Des Weiteren kann ein isolierter Anstieg der Monozyten auch als „Stressantwort“ interpretiert werden. Dies tritt beispielsweise als Reaktion auf die Gabe von Glukokortikoiden (Steroidhormone) auf.
2. Isolierter Anstieg der Monozyten nach schwerer Leukopenie
Ein isolierter Anstieg der Monozyten im Blut nach einer schweren Leukopenie (verminderte Anzahl an weißen Blutkörperchen) kann ein positives Zeichen für eine Erholung des Knochenmarks sein. Das Knochenmark ist für die Produktion von Blutzellen verantwortlich, und eine Erhöhung der Monozytenzahl deutet darauf hin, dass das Knochenmark seine Funktion wieder aufnimmt.
Es ist wichtig zu beachten, dass diese reaktiven Formen der Blutbildveränderungen verschiedene Ursachen haben können und eine genaue Diagnosestellung durch einen Arzt erforderlich ist, um die zugrunde liegende Erkrankung zu identifizieren.
Liste reaktiver Formen der Blutbildveränderungen:
– Erhöhte Monozytenzahlen bei chronischen Entzündungen
– Isolierter Anstieg der Monozyten als „Stressantwort“ auf Glukokortikoide
– Isolierter Anstieg der Monozyten nach schwerer Leukopenie als Zeichen für Knochenmarkserholung
Zusammenfassend sind Monozyten große, fressende weiße Blutkörperchen, die eine wichtige Rolle bei der Immunabwehr spielen. Sie sind Teil des angeborenen Immunsystems und können sich in Makrophagen verwandeln, um Krankheitserreger zu bekämpfen. Durch ihre vielfältigen Funktionen tragen Monozyten zur Aufrechterhaltung einer gesunden Immunantwort bei.

